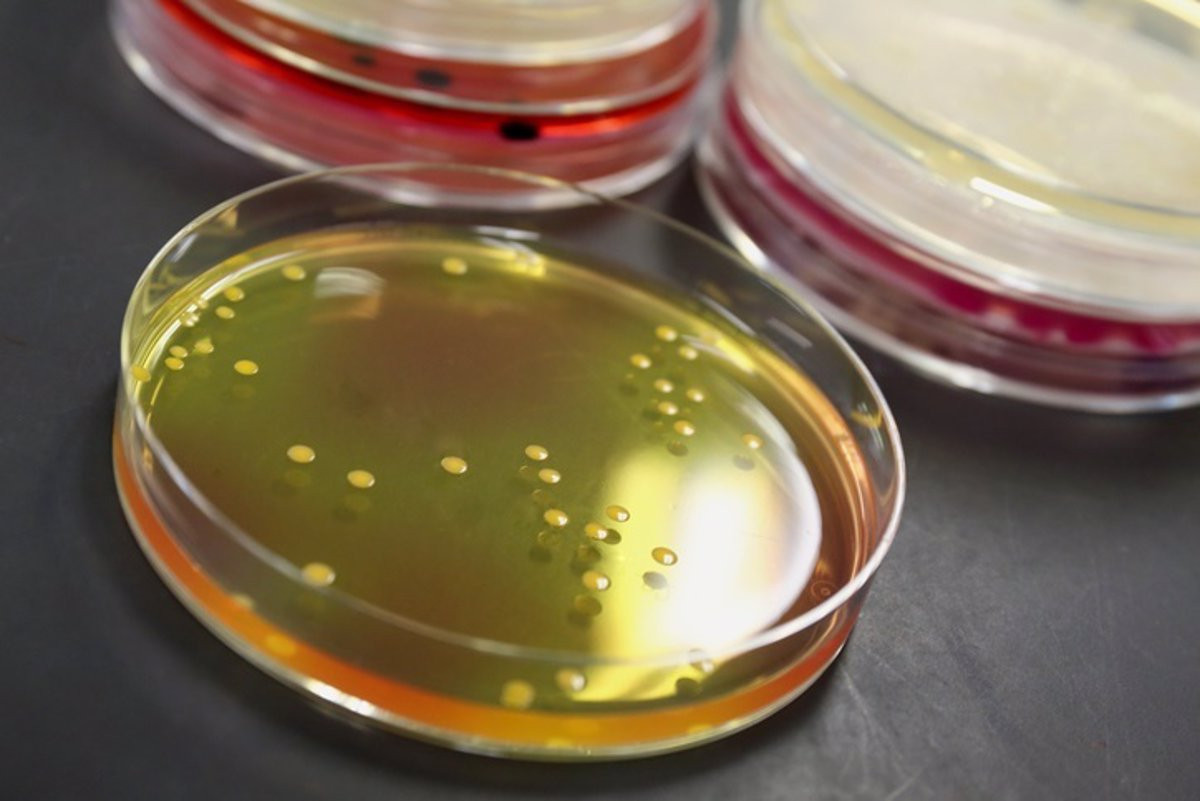
Botulismo

Alerta alimentaria por casos de botulismo, uno de ellos en Galicia, tras consumir tortilla de patata envasada
Hay cuatro casos confirmados y tres que están siendo objeto de estudio. Todos ellos habían consumido recientemente tortilla de patata envasada, que ya está siendo retirada del mercado por sus productores.
Una serie de casos de botulismo han encendido las alarmas de la Agencia Española de Seguridad Alimentaria y Nutrición (AESAN) al detectar que los enfermos comparten la particularidad de haber consumido una tortilla de patata envasada de la misma marca. Por ahora hay cuatro casos confirmados -uno de ellos en Galicia, que recibió tratamiento en la UCI- y tres casos sospechosos relacionados con la compra y consumo de este producto en distintos supermercados.
Aquellos que hayan adquirido este producto de Chef Select, Auchan, Eroski, Unide, Consum, DIA, Ametller, Condis, El Corte Inglés, Carrefour, Alipende y Rikissimo deben abstenerse de consumirlo por precaución, tal y como inciden las autoridades sanitarias, que ya han puesto la alerta en conocimiento de todas las Comunidades Autónomas y están a la espera de que "las investigaciones avancen" para concretar más aspectos sobre la causa de este brote.
"Queremos recordar a los consumidores la importancia, mayor en esta época del año por el calor, de conservar los productos alimenticios a las temperaturas de conservación indicadas en el etiquetado y seguir las instrucciones de uso indicadas por los fabricantes, ya que garantizan la seguridad de los productos para los que se establece una fecha de caducidad", agregan desde la AESAN.
"El caso de las tortillas de patata envasadas es especialmente importante, ya que puede tenerse la falsa sensación de que son como las conservas, que tienen estabilidad térmica, y mantenerlas sin refrigeración a la temperatura ambiente actual puede derivar en problemas de salud tras su consumo", apostillan.
¿QUÉ ES EL BOTULISMO?
El botulismo es una enfermedad rara pero grave, causada por una toxina producida por la bacteria Clostridium botulinum. Esta bacteria es anaerobia, lo que significa que puede sobrevivir y crecer en ambientes con poco o ningún oxígeno, como en conservas mal procesadas, alimentos enlatados, productos caseros en conserva y otros alimentos contaminados. Este sería el caso de las tortillas envasadas bajo sospecha.
La toxina del botulismo es una de las sustancias más potentes conocidas y puede afectar el sistema nervioso, provocando síntomas graves y potencialmente mortales. Los síntomas suelen incluir debilidad muscular, visión borrosa, dificultad para tragar y hablar, sequedad en la boca y, en casos graves, puede llevar a la parálisis respiratoria, lo que requiere atención médica urgente. De padecer alguno de estos síntomas y haber consumido el producto en cuestión recientemente, es aconsejable acudir a un centro de salud lo más pronto posible.
El botulismo se trata con antitoxinas que neutralizan la toxina antes de que cause daño irreversible. También pueden ser necesarios tratamientos de apoyo, como asistencia respiratoria si los músculos respiratorios están afectados. Para prevenir el botulismo, es importante seguir buenas prácticas de higiene y seguridad alimentaria, especialmente al enlatar o conservar alimentos en casa. Además, se recomienda evitar dar miel a bebés menores de un año, ya que puede contener esporas de C. botulinum que pueden provocar botulismo infantil. En general, es fundamental seguir las pautas de seguridad y procesamiento adecuado de los alimentos para evitar la contaminación y la producción de toxina botulínica.
RETIRADO DEL MERCADO
A raíz de lo sucedido, desde el Grupo Palacios Alimentación han tomado la determinación, voluntaria y por precaución, de retirar sus productos de tortilla de patata envasada. Con todo, desde la firma indican que se han tomado "todas las medidas necesarias para detectar una posible causa", lo que no ha evitado el paro de la producción en las instalaciones en las que se fabrica el producto, donde se han realizado hasta cuatro análisis con resultado favorable para las autoridades sanitarias.
Hasta ahora, la AESAN "no ha podido establecer una evidencia, ni en los productos ni en los procesos, que relacionen causa efecto", pero la compañía pide a sus clientes que no consuman los alimentos adquiridos y los devuelvan al punto de venta para el reembolso del precio, resaltando que para el grupo la seguridad alimentaria es un aspecto "prioritario", con controles de calidad periódicos para reforzar la seguridad. De igual manera, pide disculpas a sus compradores y reitera su colaboración con las autoridades "para aclarar este episodio cuanto antes".








Escribe tu comentario